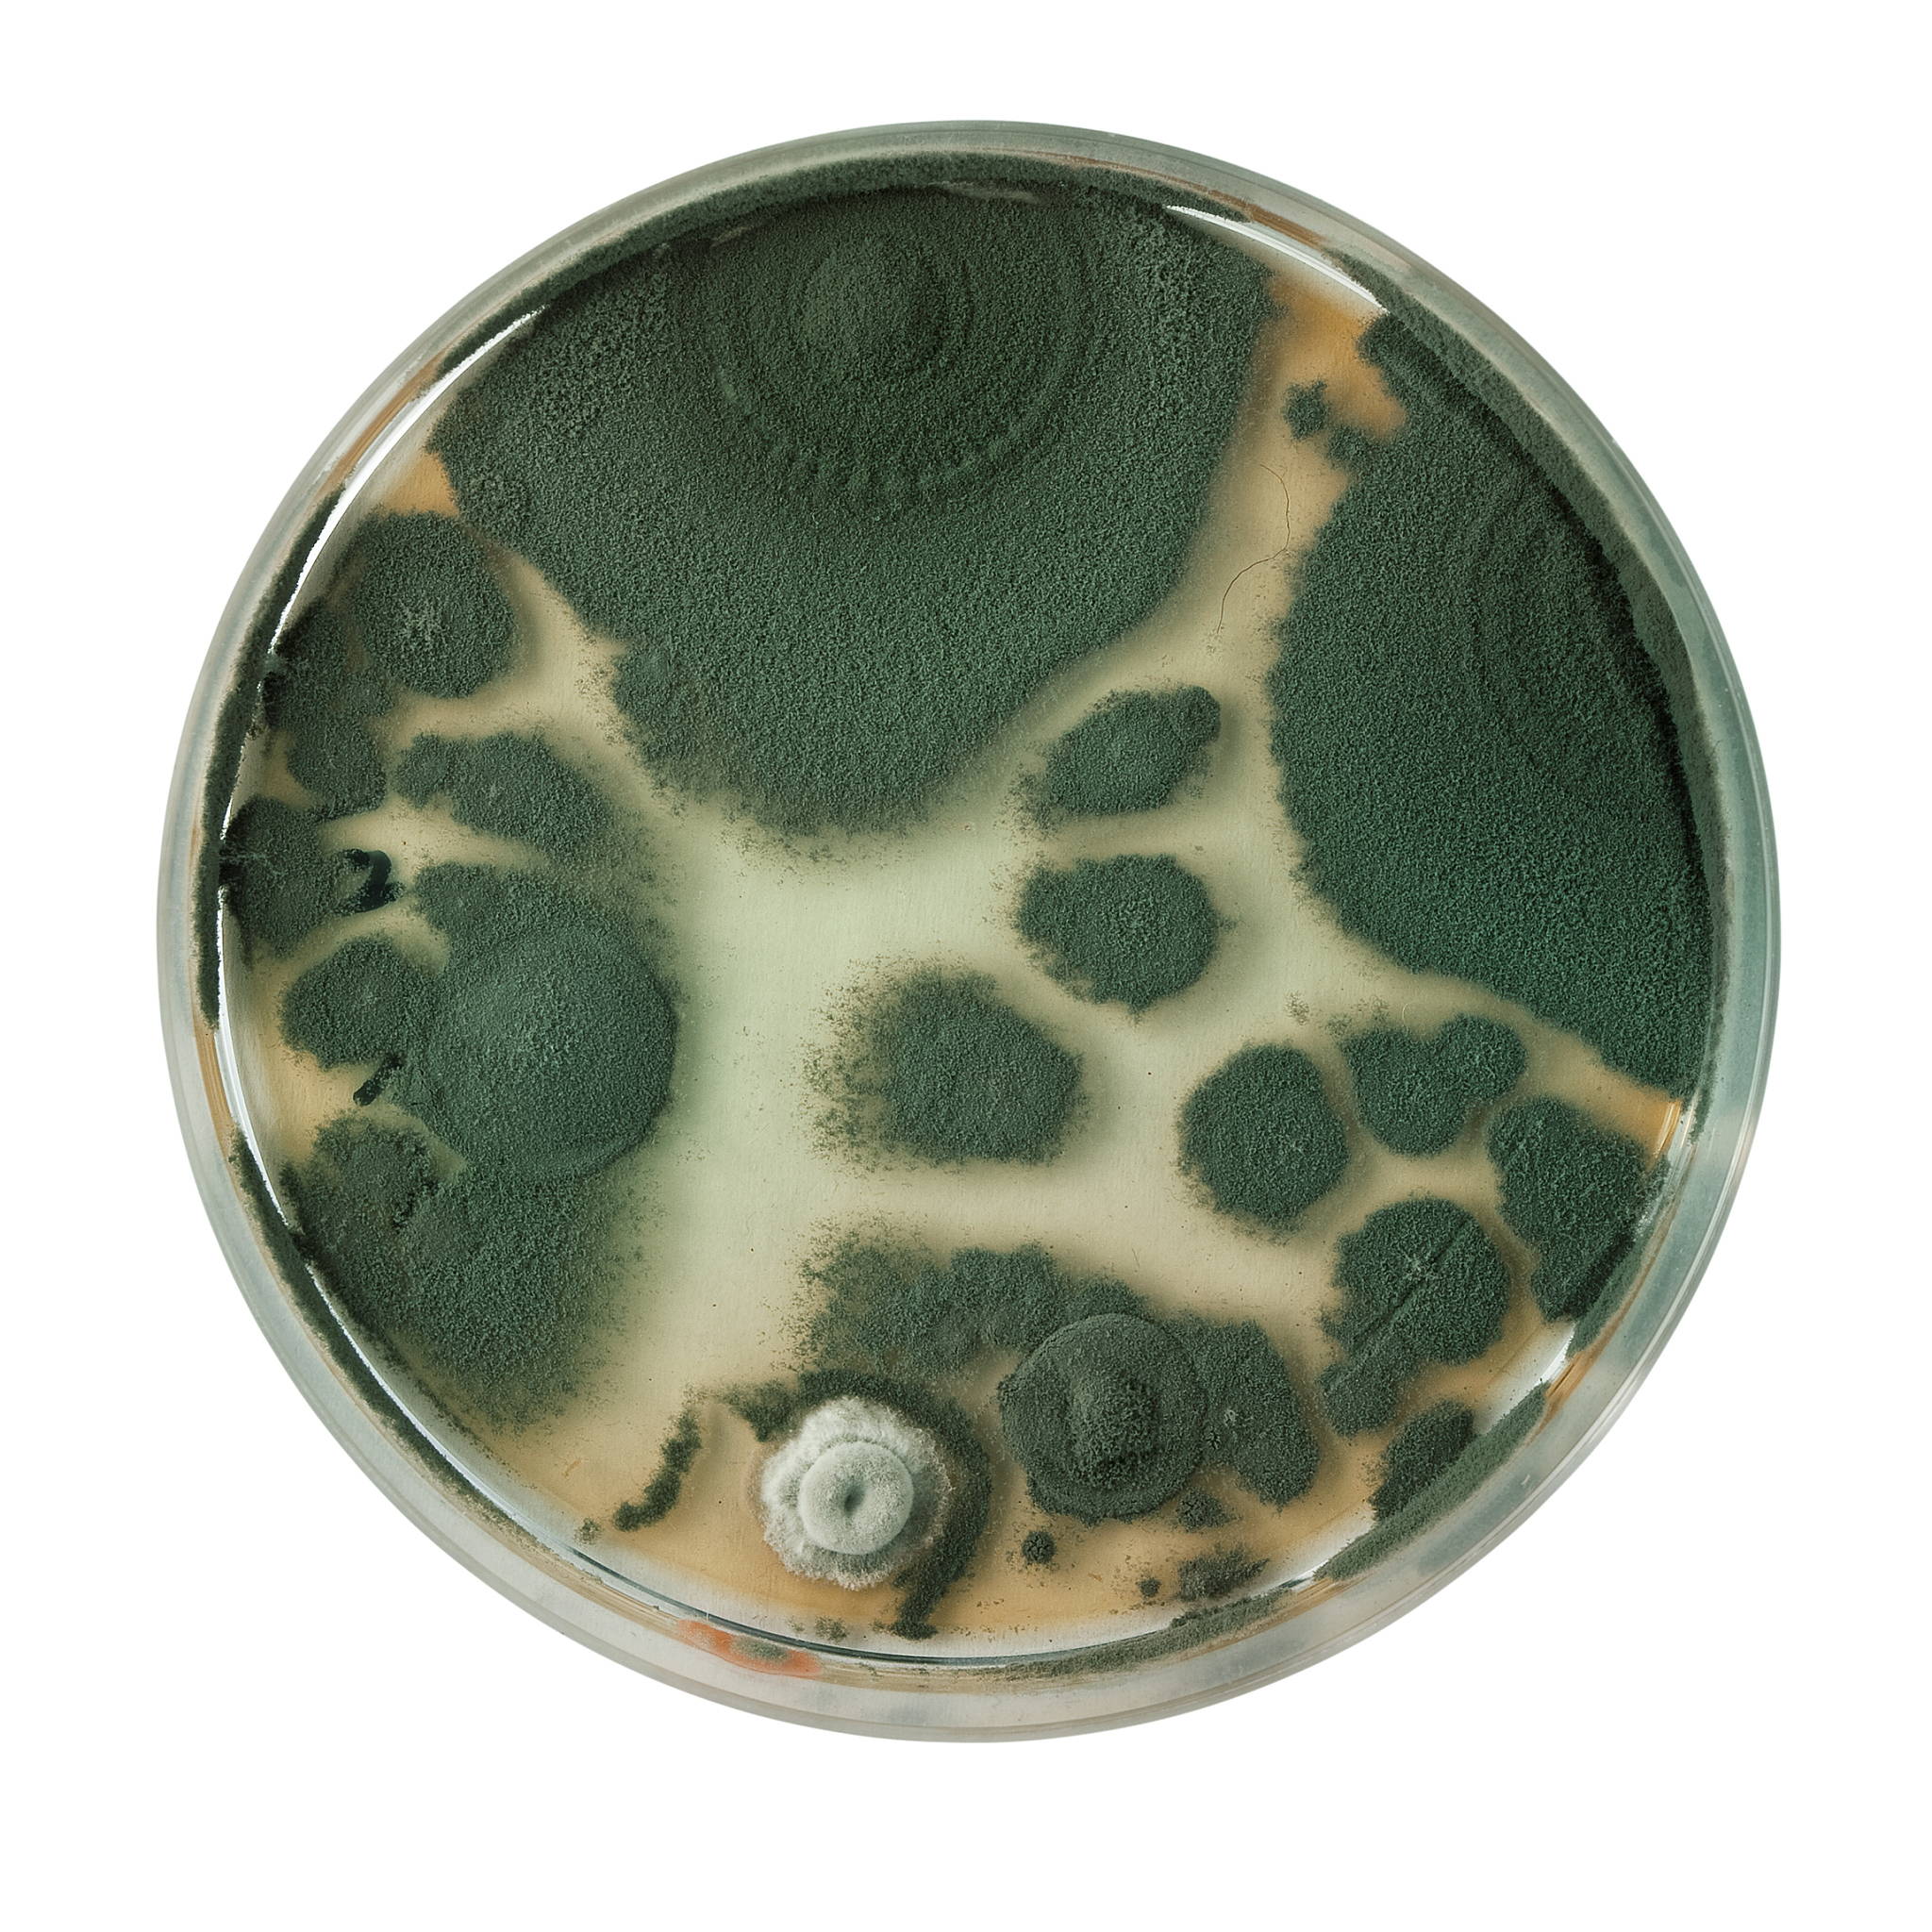
平板菌落计数法：优缺点分析及应用场景

平板菌落计数法:优缺点分析及应用场景
平板菌落计数法是微生物学中常用的方法之一,通过在培养基上培养微生物,观察并计数形成的菌落,来估算样品中微生物的数量。该方法简单易行,但同时也存在一定的局限性。
优点:
- 可以直观地观察和计数微生物的数量;
- 可以很快地确定微生物的数量,适用于快速确定微生物的数量;
- 便于比较不同样品中微生物数量的差异。
缺点:
- 无法区分不同种类的微生物,例如无法区分细菌和真菌;
- 不能对微生物进行定量分析,只能得出菌落数量;
- 可能会受到其他微生物或化学物质的干扰,导致计数结果偏差;
- 无法检测微生物的活性和生长状态,只能测量静态数量。
总而言之,平板菌落计数法是一种简单有效的微生物检测方法,适用于快速估算微生物数量的场景。但需要注意该方法的局限性,在实际应用中应结合其他方法进行验证和补充。
原文地址: http://www.cveoy.top/t/topic/oawa 著作权归作者所有。请勿转载和采集!